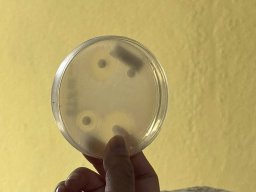
18 - 24 NOV. 2024 WORLD ANTIMICROBIAL RESISTANCE AWARENESS

| 📍 | HOSPITAL TENGKU PERMAISURI NORASHIKIN | |
| Jalan Semenyih 43000 Kajang Selangor Darul Ehsan |
| 📍 | PUSAT RAWATAN WANITA DAN KANAK-KANAK | |
| Hospital Tengku Permaisuri Norashikin Lengkok Jalan Semenyih 43000 Kajang Selangor Darul Ehsan |
||
| ☎️ | +603-8913 3333 | |
| 📧 | helpdeskhkjg@moh.gov.my | |
| 🌏 | jknselangor.moh.gov.my/htpn | |
| www.facebook.com/hospitalkajangofficial |
Hari Ini:
55
Minggu Ini:
781
Bulan Ini:
3,409
Jumlah Pengunjung:
1,294,531
|
|
Imbas kode QR untuk paparan mobile |